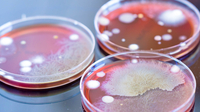

« Nous ne pouvons briser le cycle de la pauvreté que par l'éducation »
L'éducation est la clé
C'est important pour briser le cycle de la pauvreté. »
Son grand-père avait émigré de l'Inde vers Durban, dans la province orientale du KwaZulu-Natal, en Afrique du Sud, afin de gagner de l'argent pour sa famille en travaillant dans les champs de canne à sucre ; il n'a jamais terminé l'école secondaire.
Néanmoins, chaque mois, il faisait don d'une partie de son salaire pour la construction de l'école primaire de Natest – l'école où Naidoo est aujourd'hui enseignant – afin de permettre aux futurs jeunes d'apprendre.
Changement de plan
Construire une démocratie
« L'éducation est l'arme la plus puissante que vous puissiez utiliser pour changer le monde », a souligné Nelson Mandela, alors Président de la République, premier président sud-africain à avoir été élu dans le cadre d'une élection démocratique pleinement représentative.
Intégrer l'école primaire de Natest
On estime que 80 % des 600 élèves qui fréquentent les écoles primaires de Durban viennent des zones rurales, la plupart issus de foyers défavorisés, et que moins de 34 % des parents paient des frais de scolarité.
Ces défis fournissent à Naidoo et à ses collègues une motivation supplémentaire pour s'assurer que les apprenants sont équipés des outils, des connaissances, des compétences et des attitudes qui leur permettront de réaliser leur plein potentiel et d'avoir un impact positif, tant sur le plan personnel que sur celui de leur communauté.
Soutien supplémentaire avant les heures de cours
Ces séances de tutorat ont lieu le matin, avant les heures normales de cours. M. Naidoo souhaite inciter ses élèves à exceller en mathématiques en particulier, qu'il considère comme essentielles pour réussir non seulement en Afrique du Sud mais aussi au niveau international.
Travailler avec les familles
Même en dehors des heures de classe, Naidoo est heureux de répondre aux messages des élèves et de leurs parents ou grands-parents afin de les aider à faire leurs devoirs.
Faire le maximum pour ses étudiants
Dans le cadre d'un programme destiné aux élèves défavorisés de la 12e année, Naidoo et d'autres enseignants se rendaient dans les zones rurales et reculées pendant les vacances scolaires pour donner aux apprenants des cours supplémentaires avant leurs examens finaux. Ils le faisaient à titre gracieux jusqu'à ce que le programme soit suspendu lorsque la COVID-19 a frappé le pays.
Jusqu'alors, ils avaient aidé environ 800 apprenants de cette manière, un surplus de bénévoles ayant fourni le déjeuner aux étudiants pendant cette période. Les réactions ont montré que cette aide supplémentaire avait eu un effet positif sur les résultats aux examens.
Transformer des vies par l'éducation
C'est en exploitant ce pouvoir que les enseignants du monde entier peuvent améliorer les moyens de subsistance des communautés les plus vulnérables de la planète.
Le GNLC est un réseau international axé sur les politiques qui fournit inspiration, savoir-faire et bonnes pratiques. La mission du réseau est de soutenir et d'accélérer la pratique de l'apprentissage tout au long de la vie dans les communautés du monde en promouvant le dialogue politique et l'apprentissage par les pairs entre les villes membres, en forgeant des liens, en favorisant les partenariats, en renforçant les capacités et en développant des instruments pour encourager et reconnaître les progrès dans la construction de villes apprenantes.
En savoir plus





























 « Nous ne pouvons briser le cycle de la pauvreté que par l'éducation »
« Nous ne pouvons briser le cycle de la pauvreté que par l'éducation »
 L'éducation est la clé
L'éducation est la clé
Changement de plan
Changement de plan

 Construire une démocratie
Construire une démocratie

 Intégrer l'école primaire de Natest
Intégrer l'école primaire de Natest

 Soutien supplémentaire avant les heures de cours
Soutien supplémentaire avant les heures de cours

 Faire le maximum pour ses étudiants
Faire le maximum pour ses étudiants
 Transformer des vies par l'éducation
Transformer des vies par l'éducation

